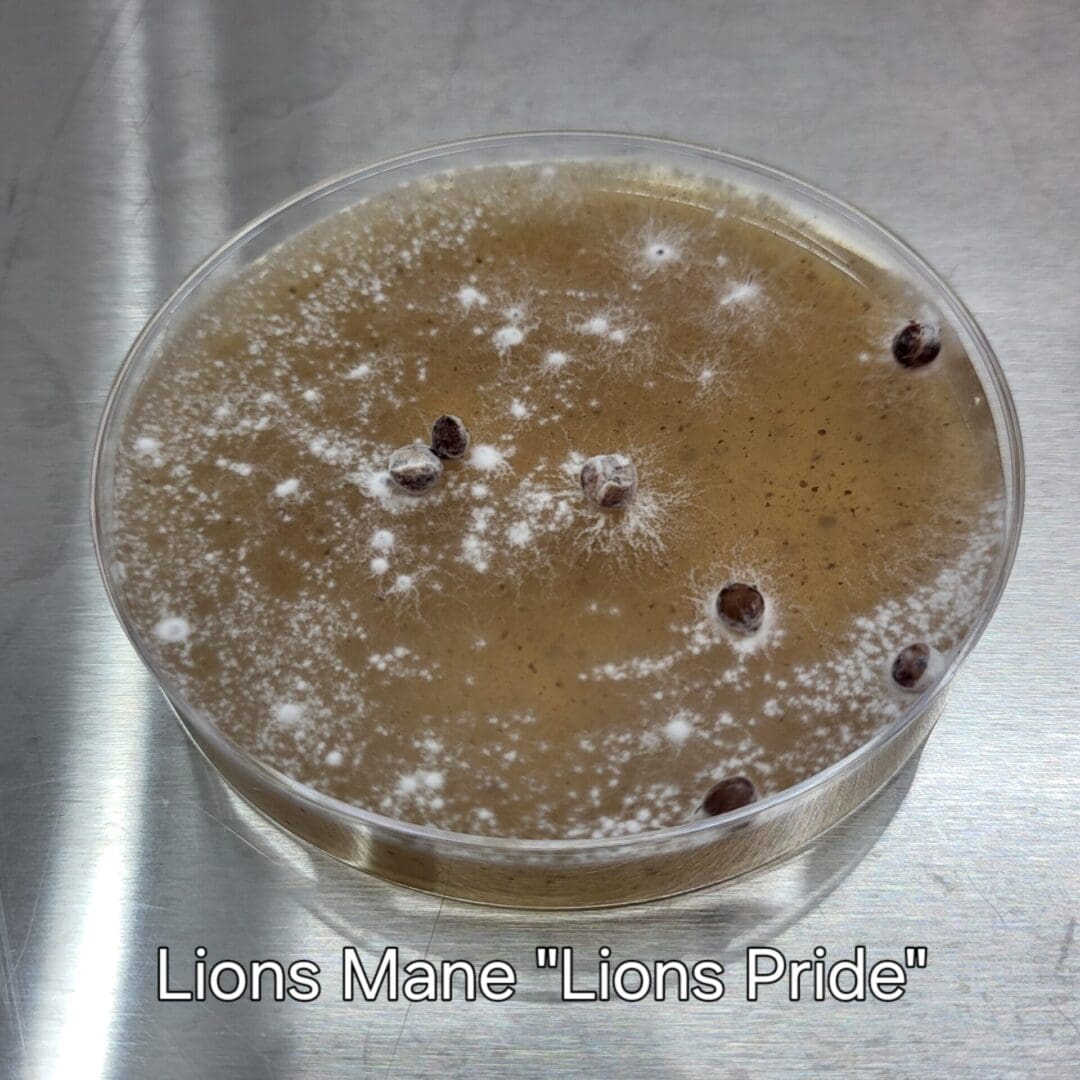
Colonized Agar Plate - Image 3
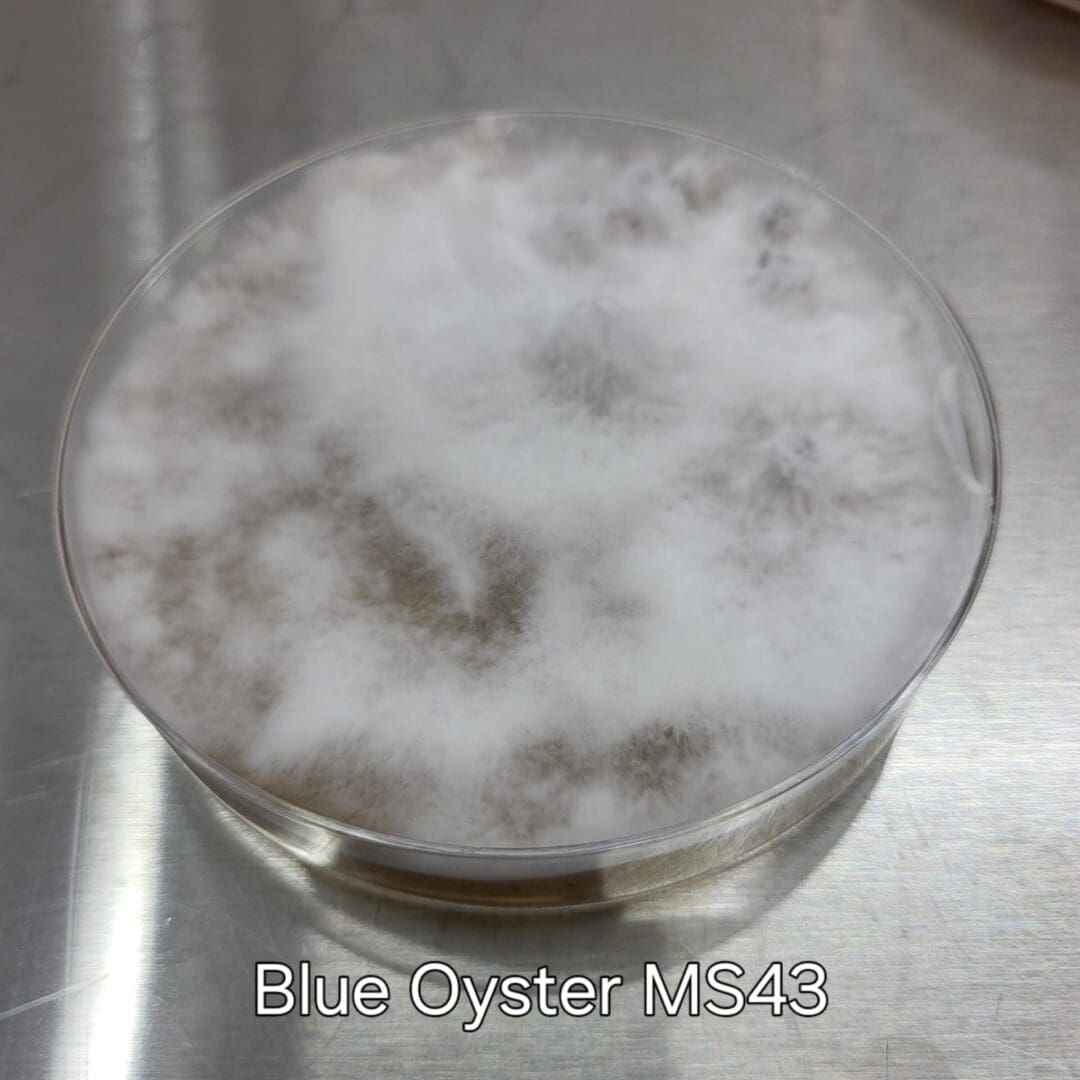
Colonized Agar Plate - Image 4
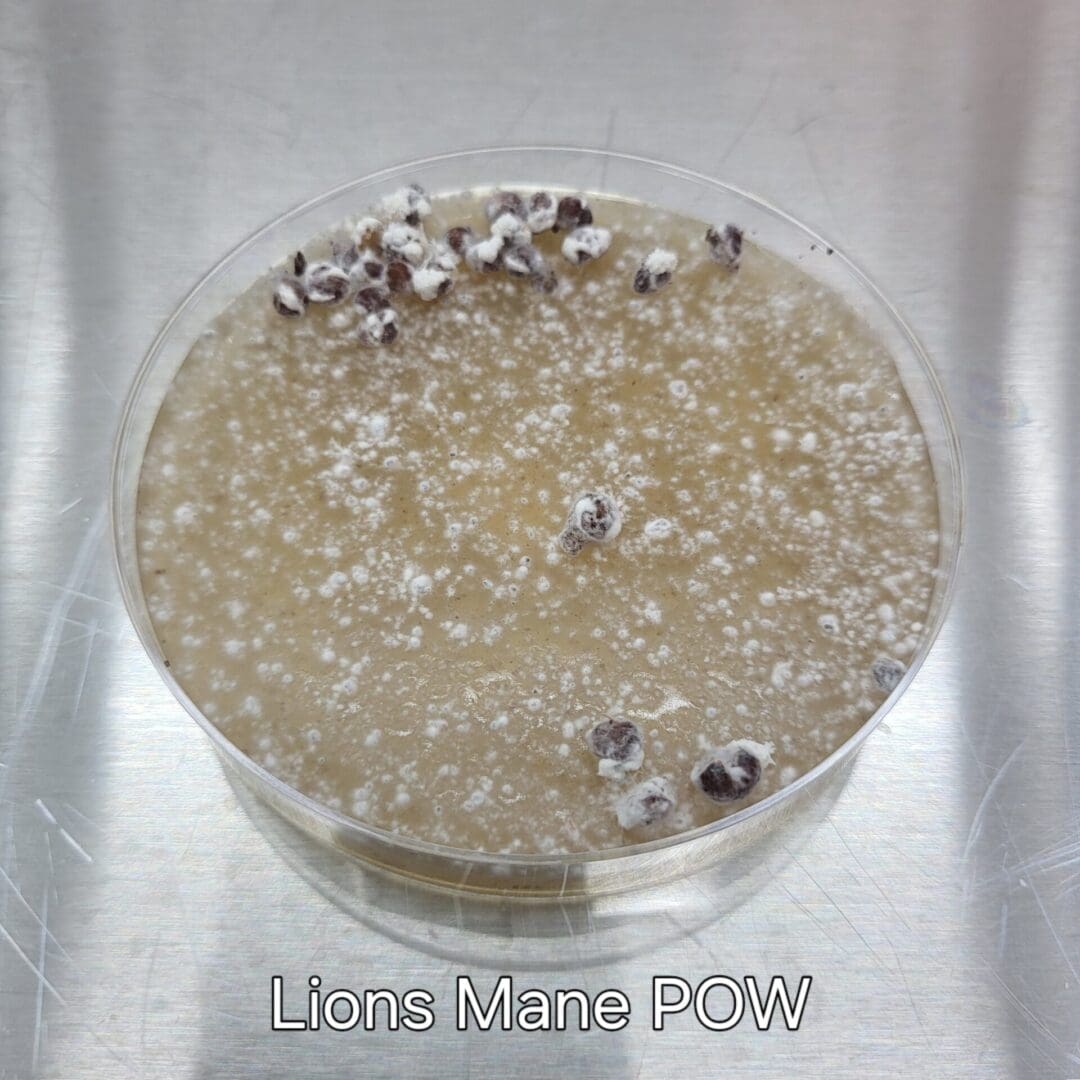
Colonized Agar Plate - Image 6
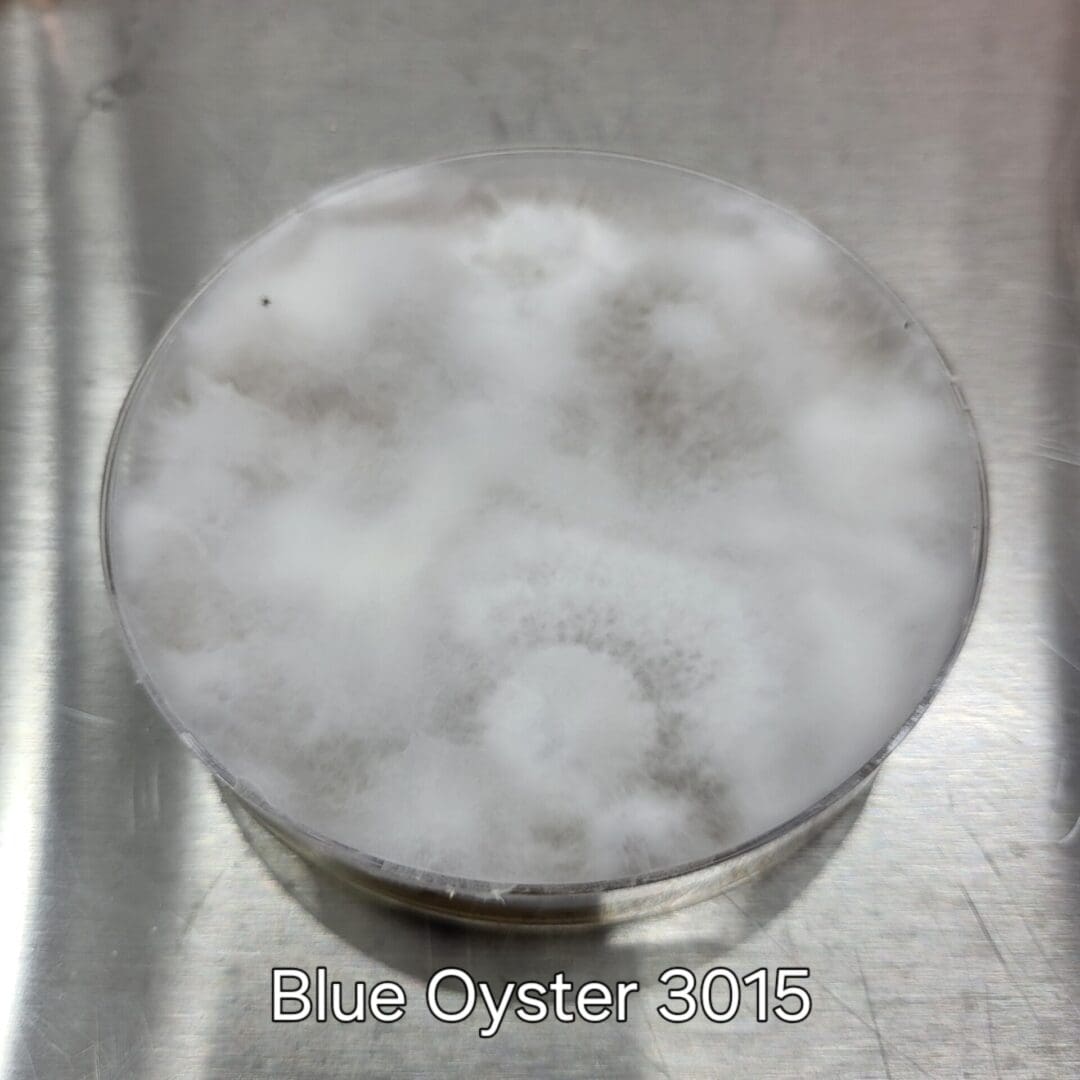
Colonized Agar Plate - Image 7
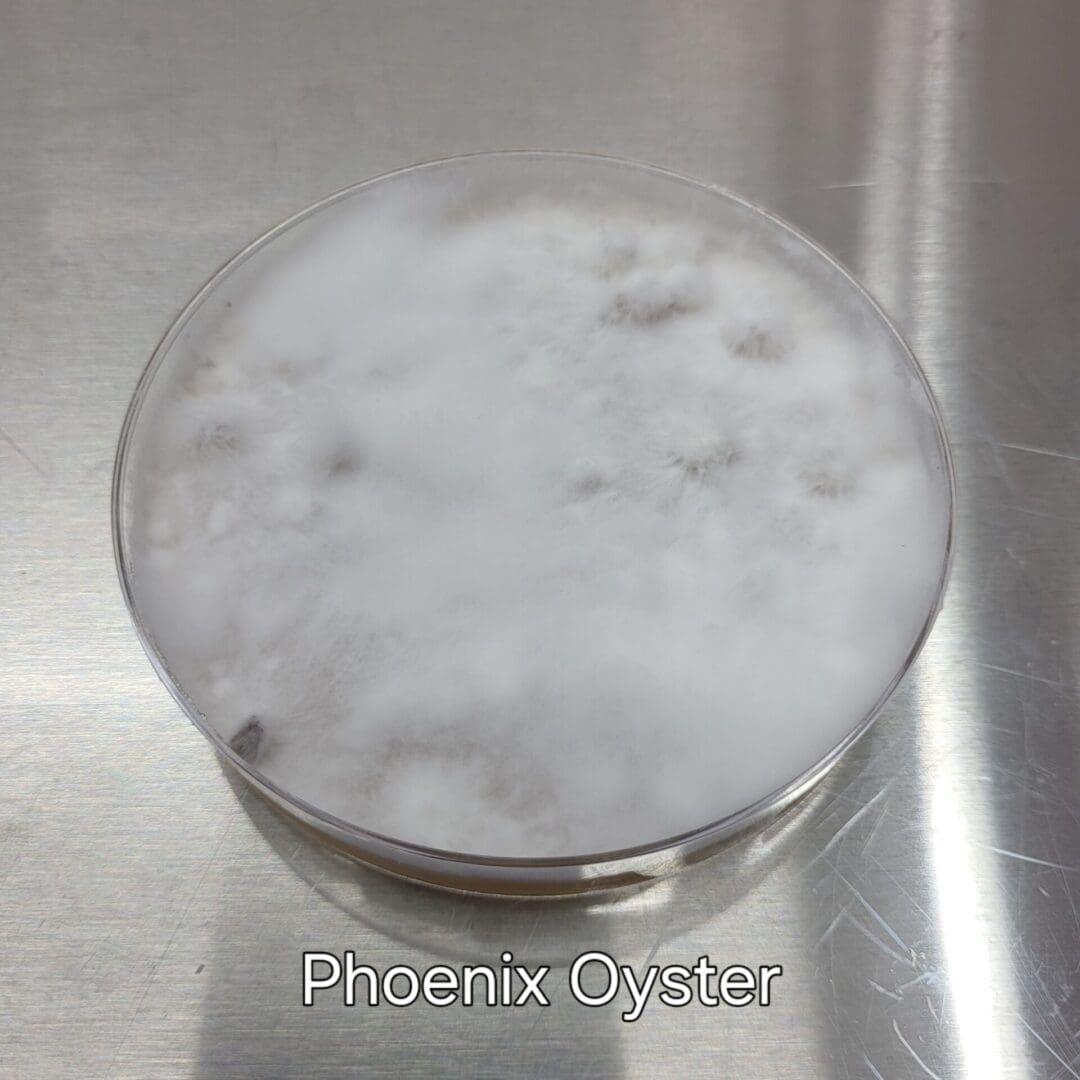
Colonized Agar Plate - Image 9
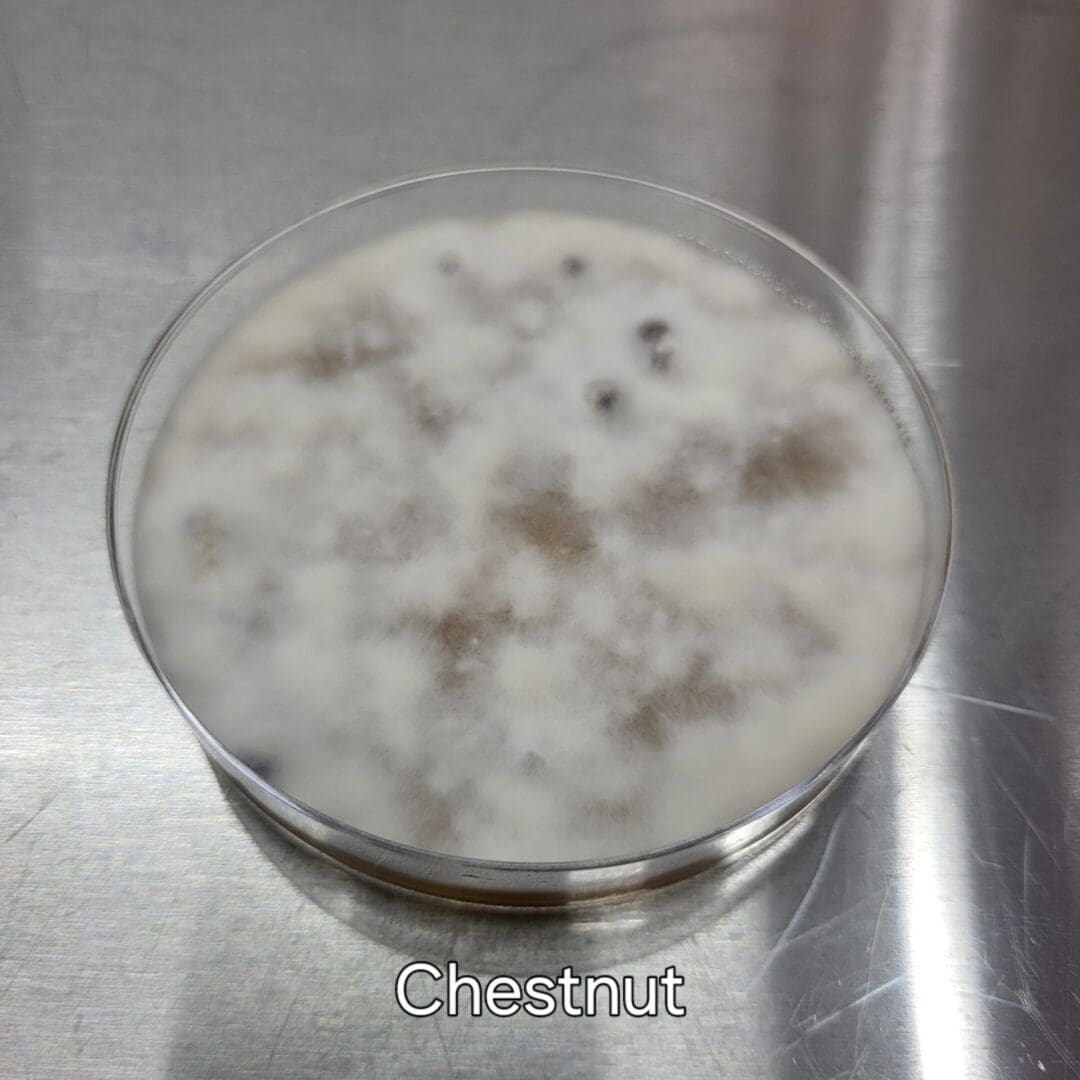
Colonized Agar Plate - Image 11
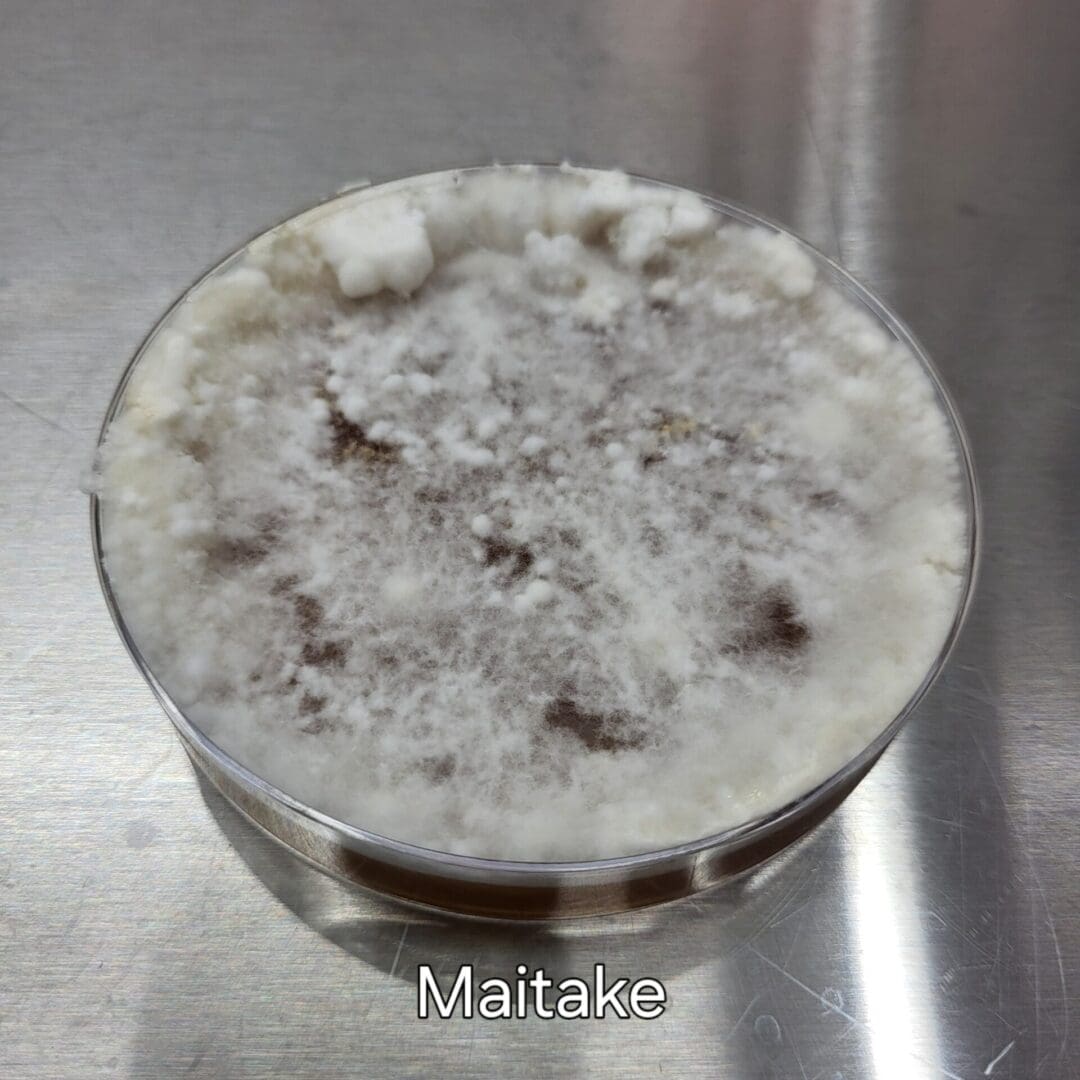
Colonized Agar Plate - Image 12
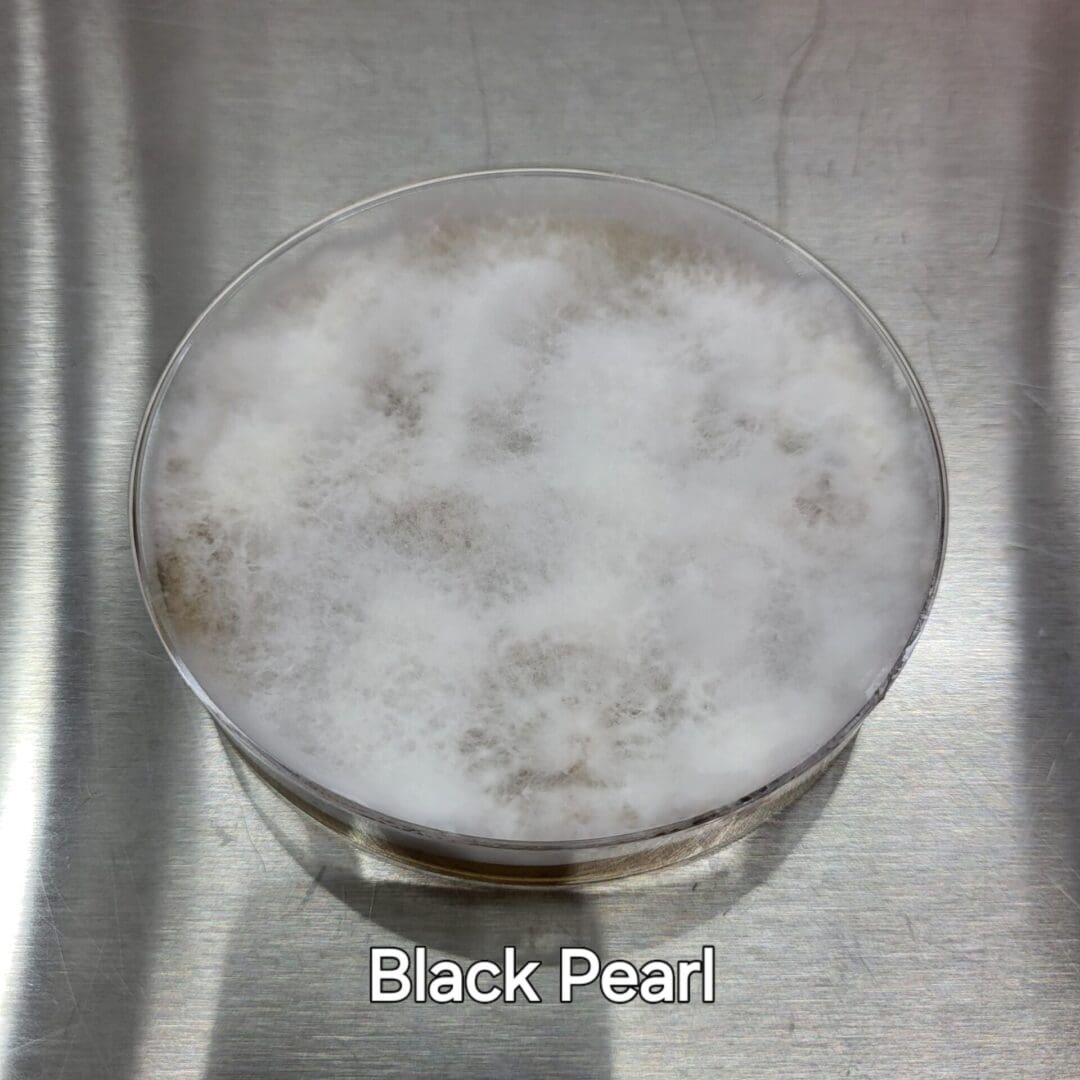
Colonized Agar Plate - Image 13
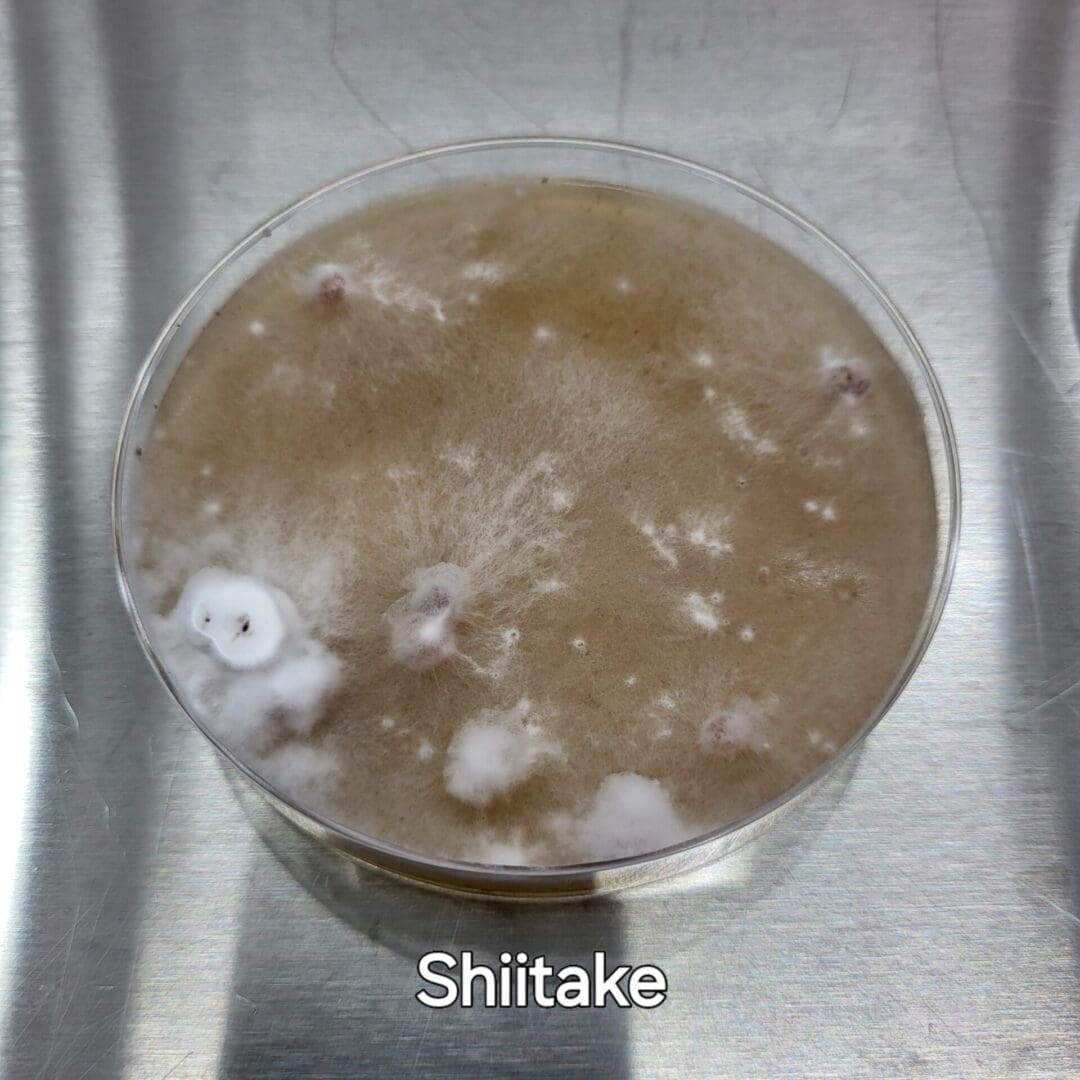
Colonized Agar Plate - Image 14

Colonized Agar Plate
$35.00
Description
One fully colonized agar plate with gourmet mushroom culture. May contain grain kernels and sawdust alongside mycelium. Visually inspected to be free of contamination or other defect at the time of delivery. To ensure optimal healthy growth, it is recommended to transfer mycelium onto separate agar plate before using to inoculate substrate. Ships in 1-2 weeks. Choose our medium cooler if you would like this shipped refrigerated Coolers and Ice packs for Spawn – Myers Mushrooms
Additional information
| Weight | N/A |
|---|

Reviews
There are no reviews yet.